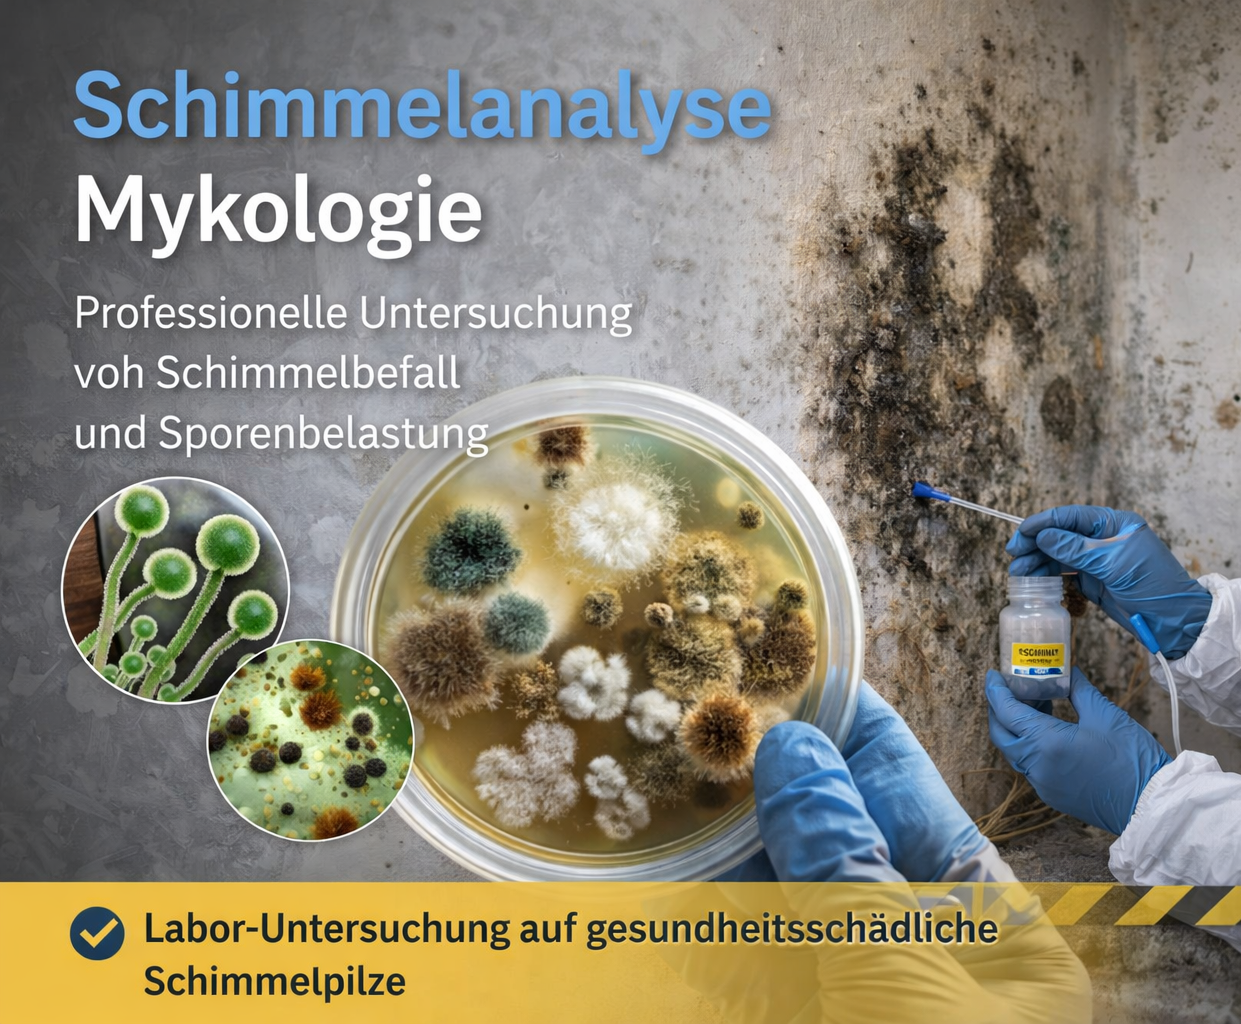

24h Notdienst bei Wasserschaden in der Wetterau, MKK, Gießen und Umgebung – Professionelle Leckageortung, Trocknung & Sanierung vom Fachbetrieb
Schnelle Hilfe im Notfall – rufen Sie uns jetzt an!
Jetzt WhatsApp schreiben – wir antworten sofort!
Einfach per WhatsApp kontaktieren – schnell & unkompliziert
Jetzt Anfrage senden – wir melden uns schnellstmöglich!
Jetzt Kontakt aufnehmen – schnell & unkompliziert
Schnelle Hilfe für Privatpersonen, Versicherungen & Hausverwaltungen
Technische Kompetenz für strukturierte Schadenabwicklung
Wasserschäden erfordern schnelle, professionelle und nachvollziehbar dokumentierte Lösungen.
Insbesondere bei komplexen Leitungswasserschäden ist eine fundierte Ursachenanalyse entscheidend, um Folgeschäden und unnötige Kosten zu vermeiden.
Rohrbruch Express Wetterau unterstützt Versicherungsagenturen, Versicherungsmakler, Hausverwalter, SHK-Betriebe sowie private und gewerbliche Auftraggeber mit fachlich strukturierter Schadenbearbeitung – von der präzisen Leckortung bis zur vollständigen technischen Sanierung.

Privatkunden
Wasserschaden? Wir sind schnell für Sie da!
In der Regel sind wir innerhalb von unter 60 Minuten bei Ihnen vor Ort.
🚗 Schnelle Anfahrt im gesamten Wetteraukreis sowie in:
- Main-Kinzig-Kreis (MKK)
- Kreis Gießen
- Vogelsbergkreis
- Frankfurt am Main

Hausverwaltung
„24/7-Notdienst für Ihre Objekte – kompetent, schnell und zuverlässig. Unser Ziel: Einsatz vor Ort innerhalb von 60 Minuten. Dabei legen wir großen Wert auf eine unkomplizierte und effiziente Zusammenarbeit mit Hausverwaltungen.“

Versicherungsmakler
Wir unterstützen Sie im Schadensfall mit schneller Einsatzbereitschaft, klarer Kommunikation und vollständiger Dokumentation.

Versicherungsagentur
Wir unterstützen Sie und Ihre Kunden im Schadensfall mit schneller Einsatzbereitschaft und sauberer Dokumentation.

SHK Betriebe
Effiziente Zusammenarbeit im Notfall: Leckageortung, Schadensbegrenzung und schnelle Einsatzzeiten.

Partnersuche
Zur Verstärkung unseres Teams und zur Erweiterung unseres Netzwerks suchen wir:
🔧 Mitarbeiter (m/w/d) im Bereich Leckortung / Wasserschadensanierung
🤝 Kooperationspartner (z. B. Installateure, Hausverwaltungen, Handwerksbetriebe)
Warum RohrbruchExpress Wetterau?
⭐ Ihre Vorteile auf einen Blick
⭐ Über 100 erfolgreiche Einsätze pro Jahr
Erfahrung aus zahlreichen erfolgreich bearbeiteten Schadensfällen
⭐ Schnelle Hilfe im gesamten Wetteraukreis & Umgebung
Im Einsatz in Wetteraukreis, MKK, Gießen, Vogelsbergkreis und Frankfurt am Main
🛠️ Über 15 Jahre Erfahrung
Fachkompetenz in Leckortung & Sanierung
⚡ Schnell vor Ort
In der Regel innerhalb von 60 Minuten bei Ihnen
🕐 24/7 Notdienst
Rund um die Uhr erreichbar – auch am Wochenende
📡 Moderne Technik
Präzise und zerstörungsarme Leckortung
Unsere Leistungen
Wir sorgen dafür, dass Ihre Immobilie nach einem Schaden schnell, fachgerecht und nachhaltig wieder in ihren ursprünglichen Zustand versetzt wird. Von der ersten Schadensaufnahme über die präzise Leckortung bis hin zur vollständigen Trocknung und Sanierung begleiten wir Sie durch den gesamten Prozess.
Dabei arbeiten wir effizient, transparent und in enger Abstimmung mit Ihnen sowie – auf Wunsch – mit Ihrer Hausverwaltung oder Versicherung. Unser Ziel ist es, Schäden frühzeitig zu erkennen, Folgeschäden zu vermeiden und den Aufwand für Sie so gering wie möglich zu halten.
Mit moderner Technik, schnellen Reaktionszeiten und einem erfahrenen Team stehen wir Ihnen rund um die Uhr zur Verfügung – damit Ihre Immobilie schnell wieder sicher und bewohnbar ist.

Leckageortung
Akustische Leckortung
Thermografie
Tracergas-Verfahren
Rauchgas-Verfahren
Rohrkamera / Endoskopie
Druckprüfung
Feuchtemessung

Feuchtemessung
- Kapazitives Messgerät → Fläche absuchen
- Thermografie → Auffälligkeiten eingrenzen
- Widerstand / CM-Messung → genaue Bestätigung
Mykoloie
Schimmel erkennen mit mobilem Labor: Leckageortung, Feuchtigkeitsmessung und Mykologie durch Rohrbruchexpress-Wetterau. Schnelle Analyse vor Ort bei Wasserschäden und Schimmelbefall.

Wiederherstellung
Zeit ist Geld – auch für unsere Kunden. Deshalb arbeiten wir in optimierten Prozessen und mit einem gut eingespielten Team. So können wir garantieren, dass wir Sie stets zeitnah bedienen können und dass es nicht zu Wartezeiten kommt.

Asbest-Gefahr!
Sicher mit Verdachtsfällen umgehen
Asbest wurde jahrzehntelang in vielen Gebäuden verwendet und ist noch heute in älteren Häusern, Wohnungen und Gewerbeimmobilien zu finden. Solange das Material unbeschädigt bleibt, ist das Risiko oft gering. Gefährlich wird es dann, wenn Fasern freigesetzt und eingeatmet werden. Deshalb ist bei Verdacht auf Asbest schnelles, aber vor allem richtiges Handeln entscheidend.
Jetzt informieren und Risiken vermeiden.
Ein Wasserschaden kann schnell große Schäden an Ihrer Immobilie verursachen. Um Folgeschäden zu vermeiden, ist schnelles und richtiges Handeln entscheidend. In diesem Ratgeber erfahren Sie die wichtigsten Sofortmaßnahmen bei einem Wasserschaden.
🚨 1. Wasserzufuhr sofort stoppen
Schließen Sie umgehend den Hauptwasserhahn, um den Wasseraustritt zu stoppen und weiteren Schaden zu verhindern.
⚡ 2. Strom abschalten
Schalten Sie die Stromversorgung im betroffenen Bereich ab. Achtung: Betreten Sie keine überfluteten Räume mit aktiver Elektrik!
🏢 3. Vermieter oder Hausverwaltung informieren
In Mehrfamilienhäusern sollten Sie sofort den Eigentümer, Vermieter oder Hausmeister benachrichtigen.
💧 4. Wasser entfernen
Entfernen Sie stehendes Wasser so schnell wie möglich. Bei größeren Wassermengen kann die Feuerwehr helfen.
🪑 5. Möbel und Inventar sichern
Bringen Sie Möbel, Elektrogeräte und Wertgegenstände in trockene Bereiche, um Schäden zu minimieren.
📸 6. Schaden dokumentieren
Machen Sie Fotos und Videos aus verschiedenen Perspektiven – wichtig für die Versicherung.
Allgemeine Info
In diesem Bereich finden Sie aktuelle Themen, wichtige Informationen sowie hilfreiche Einblicke rund um Wasserschäden, Leckortung und Sanierung. Wir halten Sie über Neuigkeiten, Entwicklungen und praxisnahe Tipps auf dem Laufenden.
Egal ob aktuelle Einsätze, fachliche Hintergründe oder nützliche Hinweise zur Schadensvermeidung – hier erhalten Sie einen Überblick über alles, was für Eigentümer, Hausverwaltungen und Mieter relevant ist.
Unser Ziel ist es, Ihnen verständliche und hilfreiche Informationen bereitzustellen, damit Sie im Ernstfall schnell und richtig handeln können.

Blog & Ratgeber
In unserem Blog finden Sie hilfreiche Informationen, praktische Tipps und aktuelle Beiträge zu Rohrbrüchen, Wasserschäden und deren Vermeidung.

Aktuelles & Neuigkeiten
Immer auf dem neuesten Stand
Hier informieren wir Sie über aktuelle Einsätze, Neuigkeiten aus unserem Unternehmen sowie wichtige Entwicklungen rund um Rohrbruch und Wasserschäden.
https://www.swr3.de/aktuell/nachrichten/polygon-sanierung-wasserschaden-100.html

Einsatzberichte aus der Region
Wir haben bereits in zahlreichen Städten und Gemeinden des Wetteraukreises erfolgreich Leckageortungen durchgeführt und uns dabei als zuverlässiger, regionaler Fachbetrieb etabliert. Dazu zählen unter anderem Altenstadt, Bad Nauheim, Bad Vilbel, Büdingen, Butzbach, Echzell, Florstadt, Friedberg (Hessen), Gedern, Glauburg, Hirzenhain, Karben, Kefenrod, Limeshain, Münzenberg, Nidda, Niddatal, Ober-Mörlen, Ortenberg, Ranstadt, Reichelsheim (Wetterau), Rockenberg, Rosbach vor der Höhe, Wölfersheim und Wöllstadt.

Vermietung
Demnächst bieten wir auch die Vermietung von Trocknungs- und Baugeräten an – bleiben Sie gespannt!

Die Heiztapete
Neues Produkt in Vorbereitung
Voraussichtlich im Juni stellen wir hier unsere innovative Heiztapete vor – ideal zum Heizen, zur Schimmelprävention und zur effektiven Bauteiltrocknung.

Platzhalter
An dieser Stelle wird bald eine passende Grafik oder Checkliste für Sie bereitgestellt.
Galerie & Eindrücke
Einblicke in unsere Arbeit
Hier erhalten Sie einen visuellen Eindruck unserer Einsätze, Projekte und Ergebnisse rund um Rohrbruch, Leckortung und Sanierung.
Ratgeber
Hier stellen wir Ihnen unsere Produkte und Dienstleistungen vor. Diese Seiten werden stets aktuell gehalten. Sollten Sie trotzdem einmal nicht finden, was Sie suchen, nehmen Sie einfach Kontakt mit uns auf – wir helfen Ihnen gerne weiter.

Wichtige Sofortmaßnahmen bei einem Wasserschaden
🚨 Erste Maßnahmen im Überblick
- Wasserzufuhr stoppen
Schließen Sie sofort den Hauptwasserhahn, sofern dieser zugänglich ist. - Eigentümer / Verwaltung informieren
In Mehrfamilienhäusern sollten Sie umgehend den Vermieter, Eigentümer oder Hausmeister benachrichtigen. - Strom abschalten
Unterbrechen Sie die elektrische Versorgung im betroffenen Bereich und sichern Sie diese gegen Wiedereinschalten. - Stehendes Wasser entfernen
Entfernen Sie Wasser so schnell wie möglich. Bei größeren Schäden kann die Feuerwehr beim Abpumpen unterstützen. - Inventar sichern
Bringen Sie Möbel, Geräte und persönliche Gegenstände aus dem betroffenen Bereich in trockene Räume. - Wichtige Unterlagen schützen
Besonders im gewerblichen Bereich sollten Dokumente, Maschinen und sensible Geräte sofort gesichert werden.

Wasserschaden – Sofort-Checkliste
☐ Wasserzufuhr stoppen (Hauptwasserhahn schließen)
☐ Strom abschalten
☐ Vermieter / Hausverwaltung informieren
☐ Stehendes Wasser entfernen
☐ Möbel & Gegenstände sichern
☐ Wichtige Dokumente schützen
☐ Schaden fotografieren
☐ Notdienst kontaktieren
☐ Versicherung informieren
💡 Merksatz:
Schnell handeln = weniger Schaden + geringere Kosten

Schadstoffe & Gesundheit
Schutz vor Belastungen
Hier informieren wir Sie über mögliche Schadstoffe nach Wasserschäden oder Rohrbrüchen sowie über Maßnahmen zur sicheren Entfernung und zum Schutz Ihrer Gesundheit.
Zertifikate & Qualifikationen
Geprüfte Qualität
Hier finden Sie alle relevanten Zertifikate und Nachweise, die unsere fachgerechte Arbeit und hohen Qualitätsstandards im Bereich Rohrbruch-Service belegen.

Leckageortung im Wetteraukreis bei Wasserschaden & Rohrbruch – 24h Notdienst
Ihr Experte für schnelle Hilfe in allen Städten von Altenstadt bis Wöllstadt
Wir haben bereits in zahlreichen Städten und Gemeinden des Wetteraukreises erfolgreich Leckageortungen durchgeführt und uns dabei als zuverlässiger, regionaler Fachbetrieb etabliert. Dazu zählen unter anderem Altenstadt, Bad Nauheim, Bad Vilbel, Büdingen, Butzbach, Echzell, Florstadt, Friedberg (Hessen), Gedern, Glauburg, Hirzenhain, Karben, Kefenrod, Limeshain, Münzenberg, Nidda, Niddatal, Ober-Mörlen, Ortenberg, Ranstadt, Reichelsheim (Wetterau), Rockenberg, Rosbach vor der Höhe, Wölfersheim und Wöllstadt.
Durch unsere langjährige Erfahrung, modernste Messtechnik und ein geschultes Team sind wir in der Lage, selbst kleinste Leckagen schnell, präzise und ohne unnötige Schäden zu lokalisieren. Ob im privaten Haushalt, in gewerblichen Objekten oder in öffentlichen Einrichtungen – unsere Kunden profitieren von kurzen Anfahrtszeiten, transparenter Kommunikation und nachhaltigen Lösungen.
Als regional tätiges Unternehmen kennen wir die Besonderheiten jeder einzelnen Kommune im Wetteraukreis und können dadurch besonders effizient und zielgerichtet arbeiten. Zahlreiche positive Kundenbewertungen und Weiterempfehlungen bestätigen unseren hohen Qualitätsanspruch und machen uns zu einem starken Partner in der Region.
Unser Ziel ist es, im gesamten Wetteraukreis – von Altenstadt bis Wöllstadt – als erste Anlaufstelle für professionelle Leckageortung wahrgenommen zu werden: schnell, zuverlässig und auf höchstem technischen Niveau.
Rohrbruch Express Wetterau -
wir sind Ihr Wasserschaden - Notdienst in der Nähe von Ortenberg
Ein ein leckendes Rohr ist an sich bereits ärgerlich, wenn Sie dann aber noch auf einen kompetenten Experten warten müssen, spitzt sich die Lage unweigerlich zu. Wir sind davon überzeugt, dass Sie bei einem Schaden an Ihrer Heizung oder einer Leckage schnelle Hilfe verdient haben. Aus diesem Grund bieten wir Ihnen einen zuverlässigen, kompetenten und schnellen Wasserschaden Notdienst in der Nähe von Ortenberg. Wir garantieren Ihnen bei allen Reparaturen durch unser top-ausgebildetes Team faire Konditionen.
Wasserschaden Notdienst in der Nähe: fachliche Kompetenz trifft auf moderne Technik
Wenn Sie zum Beispiel bei einem Rohrbruch einen Notdienst in Anspruch nehmen, möchten Sie sich auf schnelle Hilfe verlassen. Mit uns ist Ihnen diese sicher. Wir sind für Sie nicht nur jederzeit erreichbar, sondern garantieren Ihnen auch eine schnelle, sichere und professionelle Schadensbehebung. Dabei können Sie sich auf eine effiziente Leckortung verlassen. Mit der Reparatur eines Lecks ist es aber nicht getan. In diesem Fall setzen wir als Sanitär-Notdienst auch auf ein durchdachtes Konzept zur Trocknung Ihres Zuhauses.
Bei einem Wasserrohrbruch baut unser Notdienst auf moderne Technologien. Sie erlauben es, mögliche Lecks schnell ausfindig zu machen und diese präzise zu identifizieren. Dadurch sparen wir Zeit, minimieren den Aufwand und schaffen die Grundlage für eine schnelle Hilfe. Sie dürfen sich darauf verlassen, dass wir die Ursache für Ihren Wasserrohrbruch mit unseren Notdienst-Experten schnell und präzise bestimmen können. So werden unnötige Zerstörungen an Wänden und Böden vermieden. Zudem lassen sich Sanierungskosten reduzieren und Folgeschäden verhindern.
Wir setzen auf eine persönliche Betreuung
Aus Erfahrung wissen wir: Bei einem Wasserschaden ist die Verunsicherung unserer Kunden groß. Einerseits wünschen sie sich eine schnelle und kompetente Hilfe. Andererseits haben sie aber auch das Bedürfnis nach einer individuellen und objektiven Beratung. Auch in diesem Fall können Sie sich auf unseren Wasserschaden-Notdienst in der Nähe verlassen. Wir setzen von Anfang an auf einen engen Austausch und klären Sie umfassend auf. So erklären wir Ihnen, welche Reparaturmöglichkeiten es gibt. Volle Transparenz garantieren wir Ihnen bei den Kosten, die auf Sie zukommen.
Schnelles Handeln zahlt sich aus
Eines können wir Ihnen versichern: Im Falle eines Wasserrohrbruchs sollten Sie keine Zeit verlieren und sich tatsächlich für kompetente Hilfe durch einen Experten entscheiden. Unsere jahrelange Erfahrung kommt Ihnen an dieser Stelle zugute. Wir kennen die Risiken, die von Wasserschäden ausgehen und können Sie über mögliche Folgeschäden und Probleme aufklären. Mit einer schnellen Reaktion können Sie umfangreiche Renovierungen und damit auch unnötig hohe Kosten vermeiden. Von unseren kompetenten Mitarbeitern werden Leckagen, aber auch Rohrbrüche und Überschwemmungen nachhaltig und zuverlässig behoben.
Unser Team steht Ihnen als Wasserschaden-Notdienst in der Nähe rund um die Uhr zur Verfügung. Innerhalb von nur einer Stunde können wir nach der Meldung am Einsatzort eintreffen und für eine fachgerechte Reparatur sorgen. So leiten wir unverzüglich alle wichtigen Schritte ein. Wir setzen für Sie auf eine Rundum-Sorglos-Lösung. So übernehmen wir die Leckortung, sind Ihr Ansprechpartner für die Sanierung und die korrekte Schadenerfassung. Damit steht einer sicheren Abrechnung bei Ihrer Versicherung nichts im Weg. Weiterhin setzen wir auf eine gezielte Trocknung. Dadurch stellen wir die Weichen für eine schnelle Rückkehr in Ihr Zuhause.
Notdienst benötigt: Welche Kosten entstehen?
Immer wieder stellen wir fest, dass Haushalte zögern, bevor sie per Notdienst einen Installateur rufen. Ein Grund dafür sind die vermuteten hohen Kosten. Sicherlich wird gerade in diesem Bereich immer wieder von schwarzen Schafen und undurchsichtig hohen Kosten gesprochen. Gern beweisen wir Ihnen aber, dass es auch anders geht. Haben Sie einen Wasserschaden, hilft unser Notdienst in der Nähe schnell, kostengünstig und zuverlässig. Wir vermeiden versteckte Kosten und klären Sie stattdessen von Anfang an transparent auf. Dies ist vor allem dann für die betroffenen Haushalte wichtig, wenn es sich bei dem Wasserschaden nicht um einen Versicherungsfall handelt und sie für die Reparatur selbst aufkommen müssen.
Warum sollte bei einem Wasserschaden der Notdienst gerufen werden?
Schnelle und zuverlässige Hilfe ist bei einem Wasserschaden wichtig und aus vielen Gründen unerlässlich. Verdichten sich Anzeichen für einen Wasserschaden, sollten Sie alles daran setzen, eine unkontrollierte Ausbreitung zu vermeiden. Wasser kann sehr tief in die Bausubstanz eines Hauses eindringen und dort für Schäden sorgen, die, wenn sie unbemerkt bleiben, mitunter gravierende Folgen haben. Besonders gefährlich ist, dass die Oberfläche trocken aussieht und sich der Wasserschaden damit also kaum vermuten lässt.
Dringt Wasser in die Bausubstanz eines Hauses ein, kann sie dort nachhaltig Schaden anrichten. Ein Problem ist die schnelle Schimmelbildung. Feuchtigkeit lässt vor allem das Schimmelrisiko sprunghaft ansteigen. Besonders gravierend sind die Folgen, wenn die betroffenen Bereiche schlecht belüftet sind. In diesem Fall können Dämmstoffe durch das Wasser dauerhaft beschädigt werden, sodass sie ihre Funktion verlieren. Auch Holz ist gegenüber Wasser empfindlich und quillt mitunter auf. Die Gebäudestruktur nimmt unter Umständen Schaden. Wenn das Wasser unbemerkt genügend Zeit hat, um sich auszubreiten, kann die Durchfeuchtung dazu beitragen, dass die Gebäudestabilität nachhaltig darunter leidet. So stellt ein Wasserschaden immer auch eine nicht zu unterschätzende Gefahr für die Statik dar.
Wichtig ist die schnelle Kontaktaufnahme mit einem Wasserschaden-Notdienst in der Nähe aber noch aus einem weiteren Grund: Die Versicherungen verpflichten ihre Kunden in der Regel dazu, schnellstmöglich Schäden einerseits zu melden und diese andererseits auch zu begrenzen. Ansonsten drohen erhebliche Einbußen beim Versicherungsschutz. Im Fall einer zu späten Reaktion kann die Versicherung die Übernahme der Reparaturkosten sogar verweigern. Dies ist auch dann der Fall, wenn sie nachweisen kann, dass der Versicherungsnehmer wichtige Sofotmaßnahmen verweigert hat, um den Schaden einzudämmen.
Gehen Sie kein Risiko ein und entscheiden Sie sich für unseren Wasserrohrbruch-Notdienst als kompetente Hilfe!
Rohrbruch Express Wetterau ist Ihr Ansprechpartner für Rohrbruch, Leckortung und Wasserschaden im gesamten Wetteraukreis.
Wir bieten schnelle Hilfe bei akuten Wasserschäden, professionelle Bautrocknung und fachgerechte Schadenssanierung.
Durch moderne Messtechnik erkennen wir Feuchtigkeitsquellen präzise und vermeiden unnötige Bauschäden.
Unser 24/7 Notdienst sorgt dafür, dass Schäden schnell begrenzt und Folgekosten minimiert werden.





























